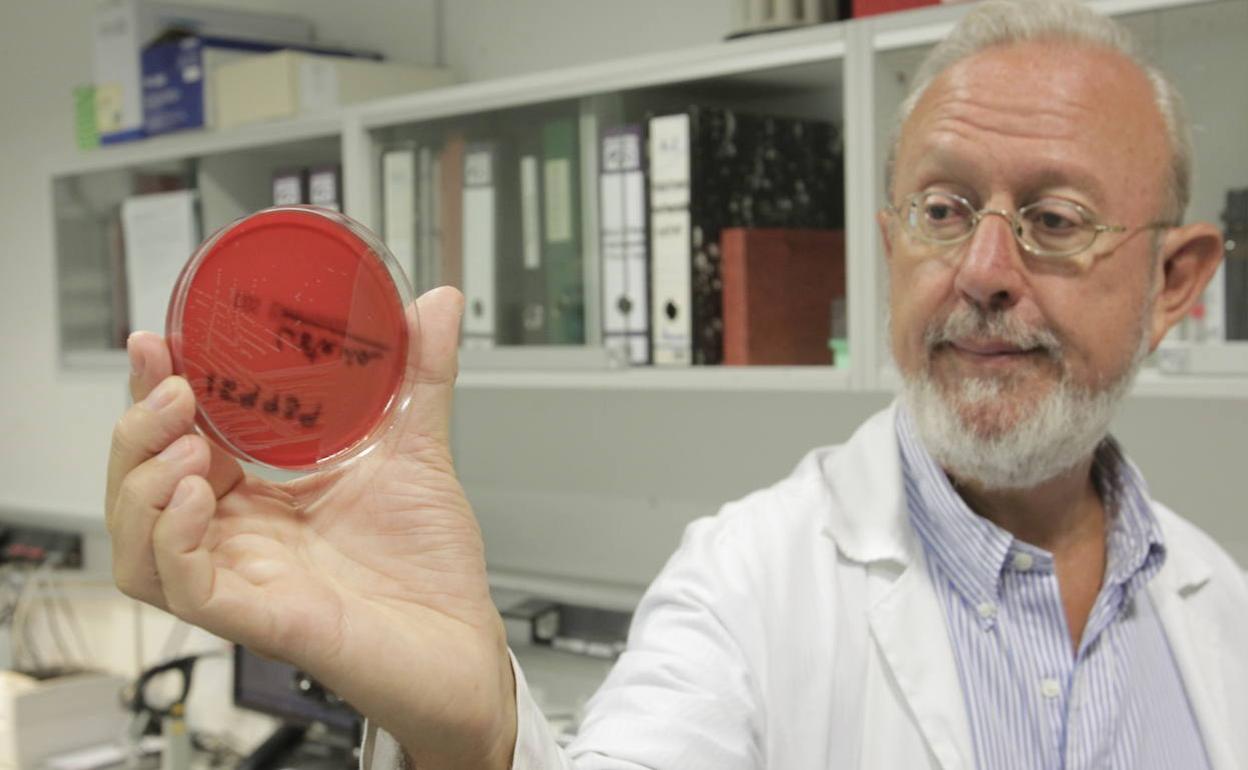
Fernando Vázquez, jefe de Microbiología del HUCA, muestra un cultivo de listeria.

La crisis de la listeria: muchas preguntas, pocas respuestas
La contaminación masiva por este brote deja dudas sobre su origen o sobre la tardanza de las autoridades en dar la alerta
Para todas las crisis alimentarias existe un protocolo que las autoridades sanitarias deben seguir, pero la gestión del brote de listeria deja muchas preguntas en el aire. «Ha sido un ejemplo de lo que no hay que hacer», asegura Beatriz Robles, tecnóloga de alimentos y experta en seguridad alimentaria. «La gestión ha podido tener defectos y si los ha habido, deberá ser un juez el que determine qué ha ocurrido», apunta Alfonso Carrascosa, científico del CSIC y experto en Seguridad Alimentaria.
¿Cómo es posible que una fábrica que produce miles de kilos de carne esté contaminada?

«Es factible que sin un proceso de limpieza y desinfección adecuado, un instrumento para mechar carne que esté contaminado con listeria pueda actuar como diseminador del patógeno», explica Ana Isabel Vitas, profesora de Seguridad Alimentaria y Microbiología de Alimentos en la Universidad de Navarra. «Puede haber fallado el programa de limpieza de la mechadora. La responsabilidad última es de la empresa, que está obligada a implementar programas de higiene para limpiar todos los días la maquinaria. Lo que ocurre es que a veces ocurren accidentes y es lo que ha podido pasar aquí», destaca Carrascosa.
¿Por qué se tardó tanto en tomar medidas?
«Tiene que haber un número de casos y un origen común. En un brote de listeriosis en Estados Unidos se tardó un mes en dar la voz de alarma. Los protocolos están perfectamente establecidos por la legislación», dice Carrascosa. «En función de si el repunte de junio era significativo o no estadísticamente, habría procedido hacer la investigación antes. Si no se hizo es porque se consideró que el aumento del número de casos no era clínicamente llamativo», agrega Robles.
¿Por qué en el laboratorio que analiza las primeras muestras hubo un error de identificación de la carne?
El consejero de Salud y Familias de la Junta, Jesús Aguirre, admitió el pasado miércoles un «desfase» de «dos o tres días» en la detección del brote de listeriosis después de que un error en el etiquetado retrasara hasta cuatro días la identificación de la carne mechada y la declaración de la alerta sanitaria. «Lo más probable es que el error de identificación se produjera en el momento de la recogida de muestras o en la entrega al laboratorio», cuenta Beatriz Robles.

¿Por qué no se retira la carne hasta el 15 de agosto?
«Por principio de precaución, se tendría que haber actuado de una forma más rápida. Existe un desfase muy importante desde el 9 de agosto, cuando se conoce que el positivo por listeria, hasta el 15, cuando se retiran los productos. Creo que la Junta quiso ser prudente y pensó en el riesgo de perjuicios para la empresa o para la industria alimentaria en general. Pero a posteriori es más sencillo verlo», sostiene Beatriz Robles.

El ministerio de Sanidad habló del riesgo de contaminación cruzada, pero la Junta lo negó. ¿Existe ese riesgo?
La contaminación cruzada es «el trasvase de microorganismos de un lugar a otro a través de un vehículo. Por ejemplo, una misma tabla de corte sin limpiar, un cuchillo, nuestras manos, los guantes de un solo uso, las bayetas o los trapos de la cocina», explica Ana Isabel Vitas. «Sí que hay riesgo de contaminación cruzada», continúa Beatriz Robles: «Yo no sé si se intentó rebajar la alarma para que las personas no acudieran a los centros de salud o si se estaba desinformando, pero en esta cuestión, se han dado versiones contradictorias y se ha producido una sensación de descontrol».
¿Cuál es el riesgo de intoxicación?
«La listeriosis se contrae exclusivamente a través de la ingesta de un alimento contaminado con la bacteria 'Listeria monocytogenes'. Por tanto, no se puede producir un contagio de persona a persona ni debemos pensar que todas las carnes que ingerimos van a estar contaminadas. Pero es normal que exista cierta psicosis ante un brote con tantos afectados, sobre todo cuando los síntomas son comunes a cualquier gastroenteritis: diarrea, vómitos, fiebre y dolor muscular. Los grupos de riesgo que manifiesten alguna sintomatología compatible con listeriosis y que hayan ingerido los alimentos bajo sospecha sí deberían acudir a los servicios de urgencias», aclara Ana Isabel Vitas.

¿Es seguro consumir carne mechada?
«Es lamentable que la gente haya dejado de consumir carne mechada. El foco está localizado y la carne afectada ha sido retirada. La población tiene que estar muy tranquila», asevera Alfonso Carrascosa. «Esta alerta sanitaria no nos debe hacer desconfiar sobre la seguridad de los alimentos. Nunca ha habido más seguridad alimentaria como en nuestros días, con vigilancia, controles e inspecciones a distintos niveles», añade Vitas.